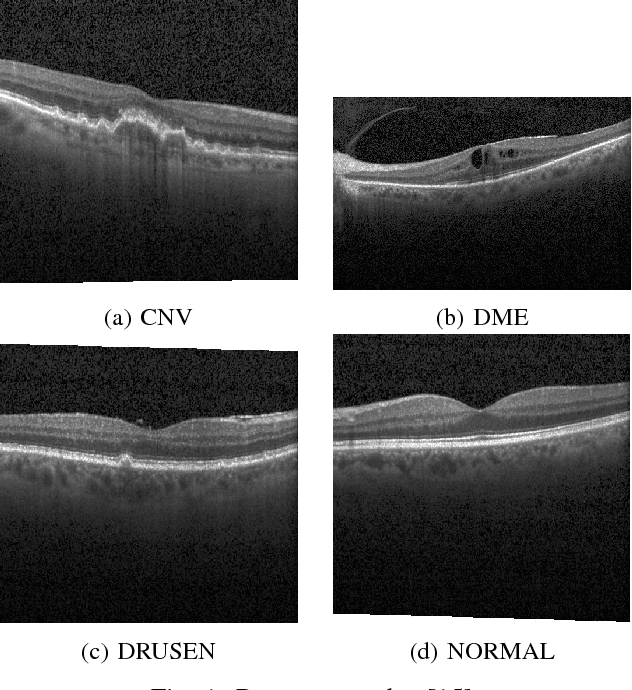
Figure 1 for A Comparison of Handcrafted and Deep Neural Network Feature Extraction for Classifying Optical Coherence Tomography Images

Abstract:Accurate diagnosis is required before performing proper treatments for coronary heart disease. Machine learning based approaches have been proposed by many researchers to improve the accuracy of coronary heart disease diagnosis. Ensemble learning and cascade generalization are among the methods which can be used to improve the generalization ability of learning algorithm. The objective of this study is to develop heart disease diagnosis method based on ensemble learning and cascade generalization. Cascade generalization method with loose coupling strategy is proposed in this study. C4. 5 and RIPPER algorithm were used as meta-level algorithm and Naive Bayes was used as baselevel algorithm. Bagging and Random Subspace were evaluated for constructing the ensemble. The hybrid cascade ensemble methods are compared with the learning algorithms in non-ensemble mode and non-cascade mode. The methods are also compared with Rotation Forest. Based on the evaluation result, the hybrid cascade ensemble method demonstrated the best result for the given heart disease diagnosis case. Accuracy and diversity evaluation was performed to analyze the impact of the cascade strategy. Based on the result, the accuracy of the classifiers in the ensemble is increased but the diversity is decreased.

Abstract:Optical Coherence Tomography allows ophthalmologist to obtain cross-section imaging of eye retina. Assisted with digital image analysis methods, effective disease detection could be performed. Various methods exist to extract feature from OCT images. The proposed study aims to compare the effectiveness of handcrafted and deep neural network features. The evaluated dataset consist of 32339 instances distributed in four classes, namely CNV, DME, DRUSEN, and NORMAL. The methods are Histogram of Oriented Gradient (HOG), Local Binary Pattern (LBP), DenseNet-169, and ResNet50. As a result, the deep neural network based methods outperformed the handcrafted feature with 88% and 89% accuracy for DenseNet and ResNet compared to 50 % and 42 % for HOG and LBP respectively. The deep neural network based methods also demonstrated better result on the under represented class.